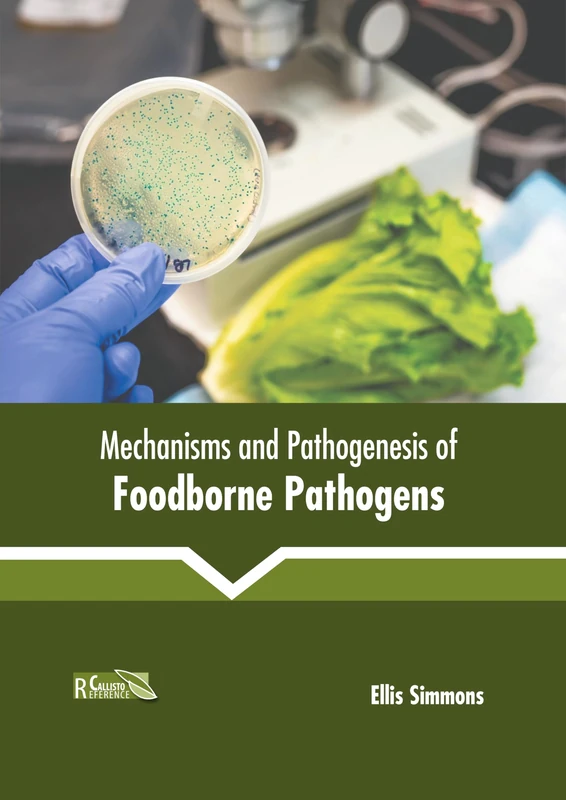
Mechanisms and Pathogenesis of Foodborne Pathogens

We can't find the internet
Attempting to reconnect
Something went wrong!
Hang in there while we get back on track

This item is currently unavailable
Human Genetics: The Basics
Price data last checked 92 day(s) ago - refreshing...
One email. No newsletter. No nudges.
Gone for 92 days. Could come back at any time — we're watching for you.
Out of stock 92 days · longest previous gap was 1 days
NEW HERE?
Amazon shows you one price. We show you all of them.
Tosheroon watches Amazon prices so you don't have to. Every product on Amazon has a price history — we make it visible. Set the price you'd actually pay, and we'll email you the second it gets there. No app, no account, one email.
WHAT'S ON THIS PAGE
when this has been cheap or pricey
where the price is heading next
all-time high & low, recent range
name your number, we'll email you
Price History & Forecast
Grey patches = out of stock. Cheaper = lower on the chart. Hover for exact prices.
No Price Data Available
Price history will appear here once data is collected from Amazon.
Price Distribution
No price data available for histogram
Product Specifications
- Format
- hardcover
- ASIN
- B0FH64N266
- Domain
- Amazon UK
- Release Date
- 25 August 2025
- Listed Since
- 10 July 2025
Barcode
No barcode data available
Similar Products You Might Like

Basic Pharmacology

Biotechnology and Genetics in Aquaculture
Animal Health and Disease

Elements of Cartography

Advances in Immunogenetics

The Golgi Apparatus

Synthetic Biology: Devices and Applications (Advanced Biotechnology)

Fundamentals of Cell Biology

Bioinformatics, Genome Analysis and Systems Biology: A Computational Approach

Bioinformatics: Methods and Applications
Mechanisms and Pathogenesis of Foodborne Pathogens

The Basics of Molecular Biology

Biosensors: Theory and Applications

Mechanisms and Applications of Interferon

Textbook of Enzyme Biotechnology

Actinobacteria: Ecology, Diversity and Applications

Cosmology: A Basic Introduction

Textbook of Environmental Pollution and Control

Principles of Physical Medicine and Rehabilitation

Physical Geography: The Basics

Plant Membrane Biology

Microbial Ecology and Biology of the Nitrogen Cycle

Medicinal Plants: From Tradition to Science
